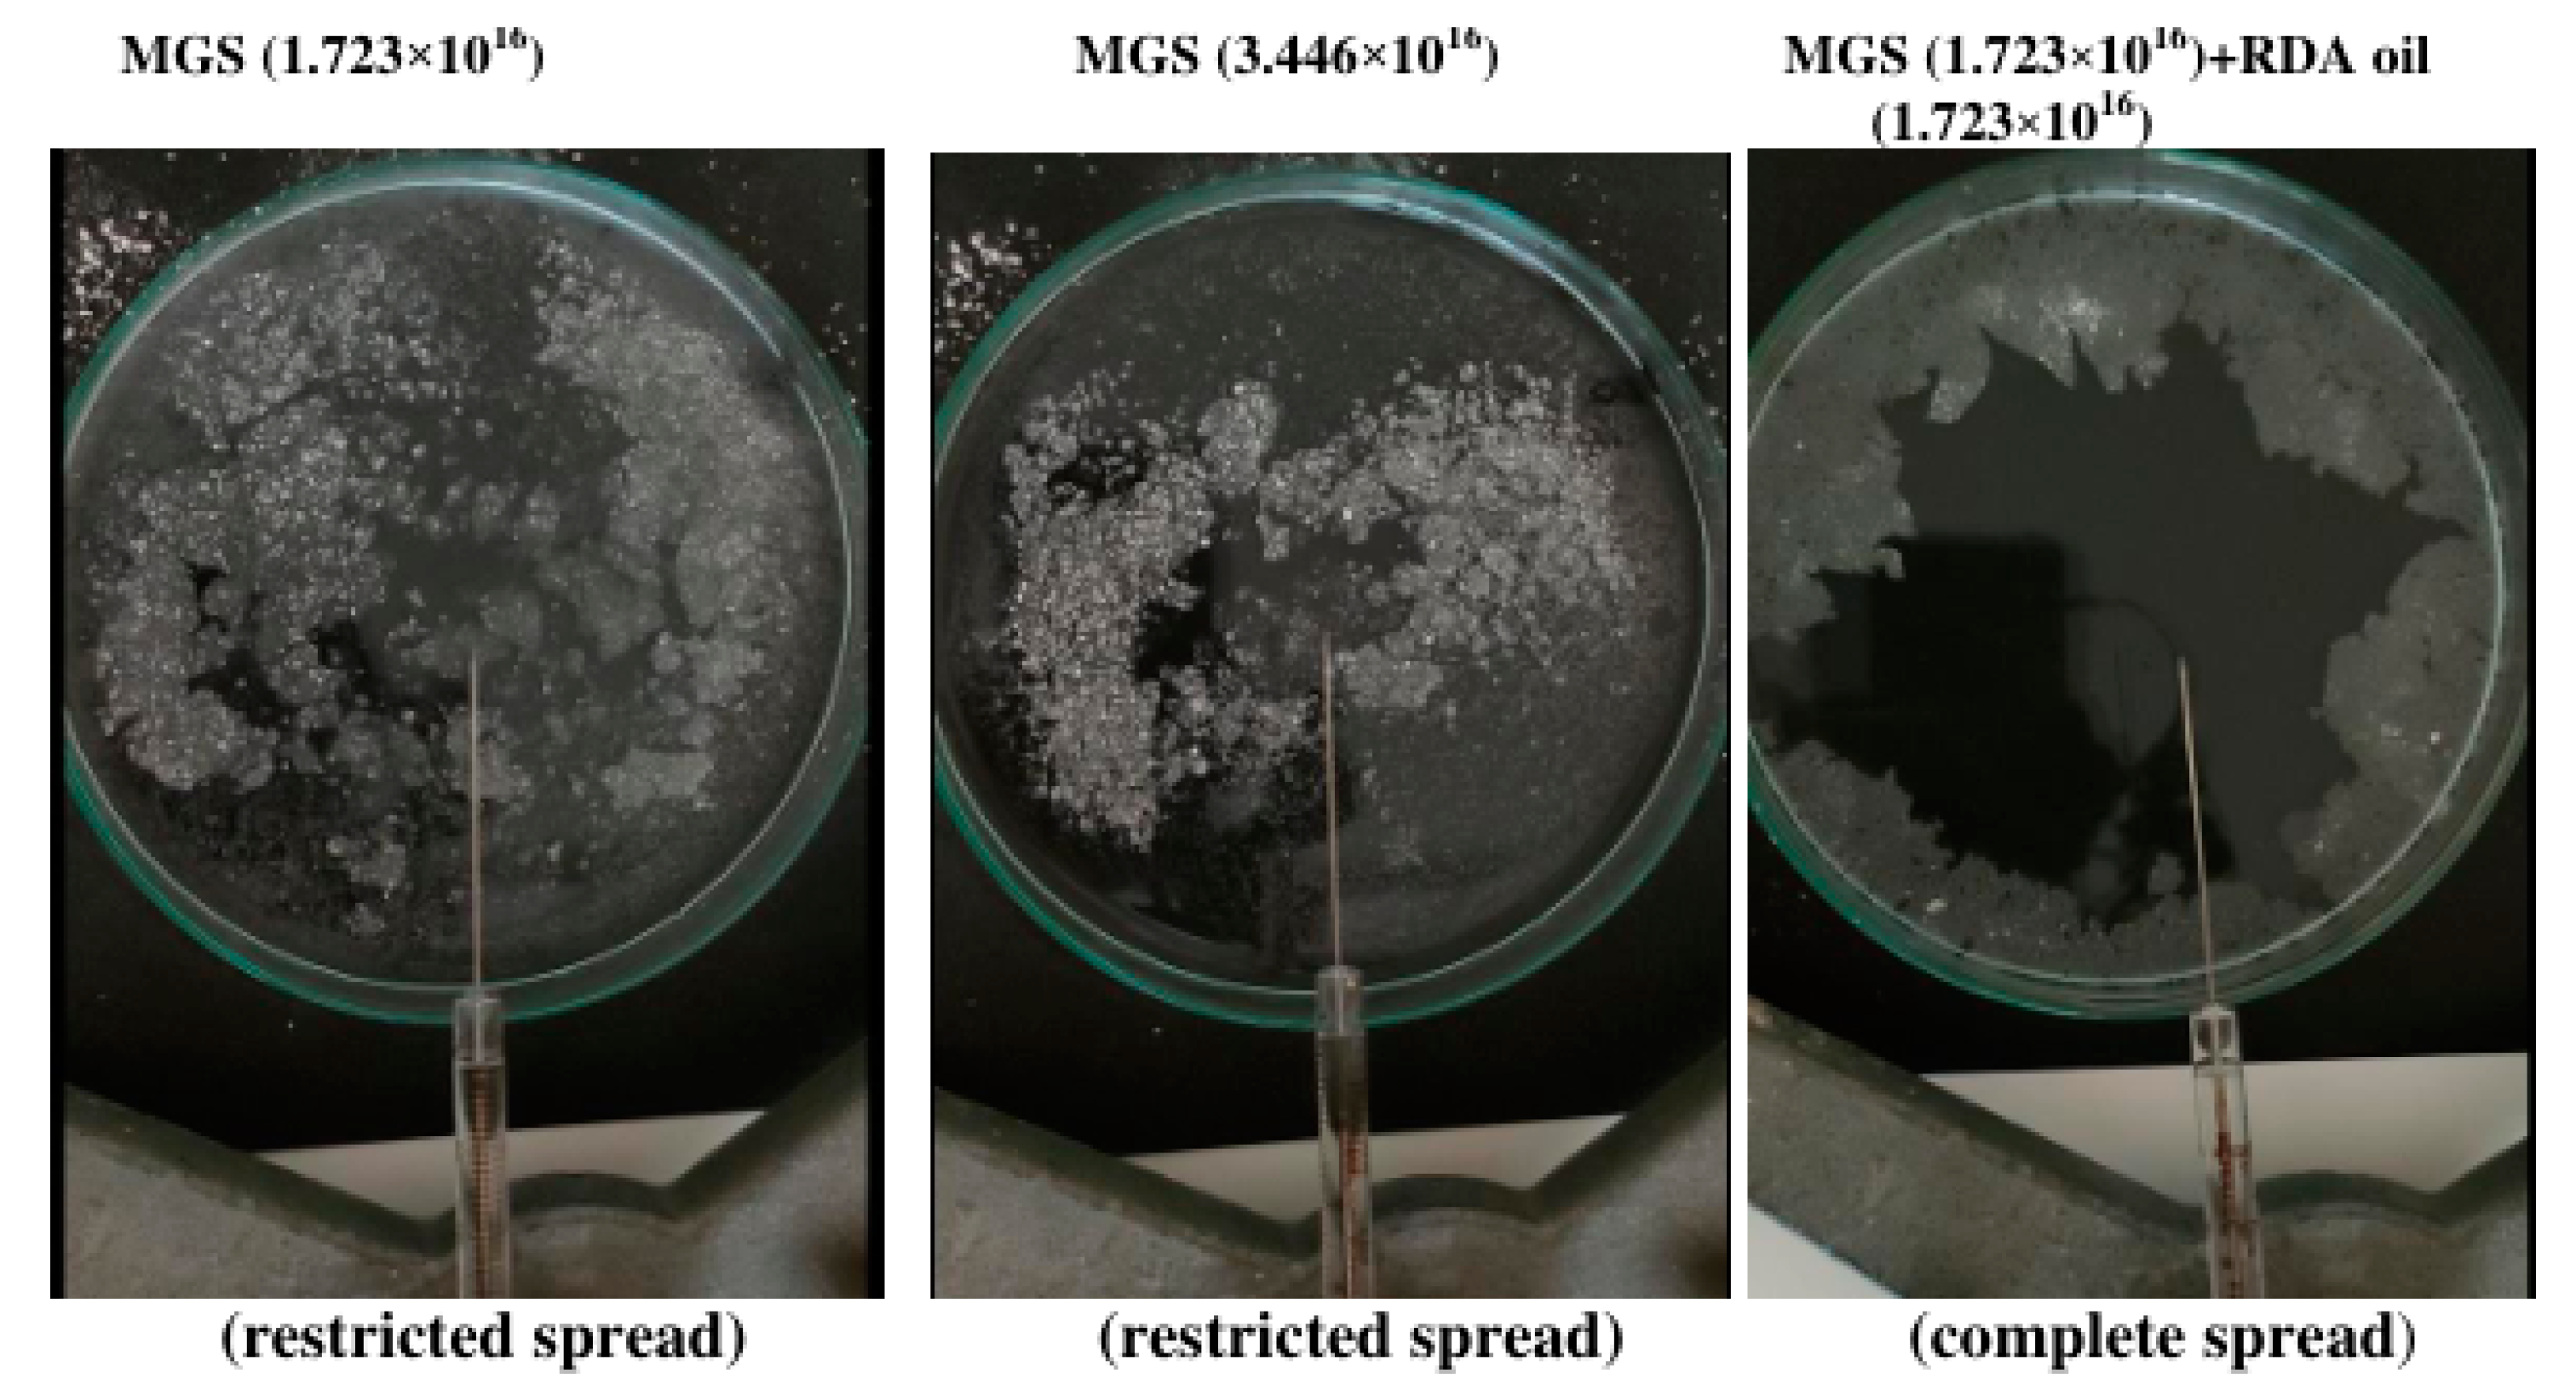
Applsci 12 12095 g007 Applsci 12 12095 g007

Langmuir Trough Study of the Interactions of Tear Mimetic Eyedrop Formulation with Human Meibum Films
Abstract
1. Introduction
2. Materials and Methods
3. Results
3.1. MGS and RDA Films at the Air/Water Interface
3.2. Pseudobinary MGS/RDA Films with Fixed MGS Amount
3.3. Pseudobinary MGS/Menthol Films with Fixed MGS Amount
4. Discussion
5. Conclusions
Supplementary Materials
Author Contributions
Funding
Institutional Review Board Statement
Informed Consent Statement
Data Availability Statement
Acknowledgments
Conflicts of Interest
Abbreviations
| AT | Aqueous tears |
| BAM | Brewster angle microscopy |
| MGS | Meibomian gland secretion (or simply meibum) |
| CO-10 | Polyoxyethylene Castor Oil 10 |
| MGD | Meibomian gland disease |
| MNT | Menthol |
| MYS-40 | Polyoxyl 40 stearate |
| NPL | Nonpolar lipids |
| OP | Oil phase |
| PL | Polar lipids |
| RDA | Rohto Dry Aid |
| SO | sesame oil |
| TF | Tear film |
| TFLL | Tear film lipid layer |
| π | Surface pressure |
| Cs−1 | reciprocal compressibility (or rigidity) modulus |
| A | Surface film area |
| Ed(t) | Transient elasticity modulus |
| t | time |
| τ | Characteristic relaxation time |
| β | Stretched exponential |
| EEQ | Equilibrium elasticity after completion of the relaxation |
References
- Willcox, M.D.P.; Argueso, P.; Georgiev, G.A.; Holopainen, J.M.; Laurie, G.W.; Millar, T.J.; Papas, E.B.; Rolland, J.P.; Schmidt, T.A.; Stahl, U.; et al. TFOS DEWS II Tear Film Report. Ocul. Surf. 2017, 15, 366–403. [Google Scholar] [CrossRef] [PubMed]
- Georgiev, G.A.; Eftimov, P.; Yokoi, N. Structure-function relationship of tear film lipid layer: A contemporary perspective. Exp. Eye Res. 2017, 163, 17–28. [Google Scholar] [CrossRef] [PubMed]
- Borchman, D.; Foulks, G.N.; Yappert, M.C.; Bell, J.; Wells, E.; Neravetla, S.; Greenstone, V. Human meibum lipid conformation and thermodynamic changes with meibomian-gland dysfunction. Investig. Ophthalmol. Vis. Sci. 2011, 52, 3805–3817. [Google Scholar] [CrossRef] [PubMed]
- Butovich, I.A. Tear film lipids. Exp. Eye Res. 2013, 117, 4–27. [Google Scholar] [CrossRef] [PubMed]
- Georgiev, G.A.; Yokoi, N.; Ivanova, S.; Tonchev, V.; Nencheva, Y.; Krastev, R. Surface relaxations as a tool to distinguish the dynamic interfacial properties of films formed by normal and diseased meibomian lipids. Soft Matter 2014, 10, 5579–5588. [Google Scholar] [CrossRef] [PubMed]
- Rosenfeld, L.; Cerretani, C.; Leiske, D.L.; Toney, M.F.; Radke, C.J.; Fuller, G.G. Structural and rheological properties of meibomian lipid. Investig. Ophthalmol. Vis. Sci. 2013, 54, 2720–2732. [Google Scholar] [CrossRef]
- Mudgil, P.; Millar, T.J. Surfactant properties of human meibomian lipids. Investig. Ophthalmol. Vis. Sci. 2011, 52, 1661–1670. [Google Scholar] [CrossRef]
- McDonald, M.; Patel, D.A.; Keith, M.S.; Snedecor, S.J. Economic and Humanistic Burden of Dry Eye Disease in Europe, North America, and Asia: A Systematic Literature Review. Ocul. Surf. 2016, 14, 144–167. [Google Scholar] [CrossRef]
- Donthineni, P.R.; Kammari, P.; Shanbhag, S.S.; Singh, V.; Das, A.V.; Basu, S. Incidence, demographics, types and risk factors of dry eye disease in India: Electronic medical records driven big data analytics report I. Ocul. Surf. 2019, 17, 250–256. [Google Scholar] [CrossRef]
- Mochizuki, H.; Yamada, M.; Hatou, S.; Tsubota, K. Turnover rate of tear-film lipid layer determined by fluorophotometry. Br. J. Ophthalmol. 2009, 93, 1535–1538. [Google Scholar] [CrossRef]
- Eftimov, P.; Yokoi, N.; Georgiev, G.A. Surface Chemistry Study of the Interactions of Sesame Oil with Meibomian Films. Molecules 2022, 27, 464. [Google Scholar] [CrossRef] [PubMed]
- Georgiev, G.A.; Yokoi, N.; Ivanova, S.; Krastev, R.; Lalchev, Z. Surface Chemistry Study of the Interactions of Pharmaceutical Ingredients with Human Meibum Films. Investig. Ophthalmol. Vis. Sci. 2012, 53, 4605–4615. [Google Scholar] [CrossRef] [PubMed]
- Georgiev, G.A.; Yokoi, N.; Nencheva, Y.; Peev, N.; Daull, P. Surface Chemistry Interactions of Cationorm with Films by Human Meibum and Tear Film Compounds. Int. J. Mol. Sci. 2017, 18, 1558. [Google Scholar] [CrossRef] [PubMed]
- Yokoi, N.; Georgiev, G.A.; Kato, H.; Komuro, A.; Sonomura, Y.; Sotozono, C.; Tsubota, K.; Kinoshita, S. Classification of Fluorescein Breakup Patterns: A Novel Method of Differential Diagnosis for Dry Eye. Am. J. Ophthalmol. 2017, 180, 72–85. [Google Scholar] [CrossRef] [PubMed]
- Grgurević, M.H.; Juretić, M.; Hafner, A.; Lovrić, J.; Pepić, I. Tear fluid-eye drops compatibility assessment using surface tension. Drug Dev. Ind. Pharm. 2017, 43, 275–282. [Google Scholar] [CrossRef]
- Dussaud, A.D.; Matar, O.K.; Troian, S.M. Spreading characteristics of an insoluble surfactant film on a thin liquid layer: Comparison between theory and experiment. J. Fluid Mech. 2005, 544, 23–51. [Google Scholar] [CrossRef]
- Nencheva, Y.; Ramasubramanian, A.; Eftimov, P.; Yokoi, N.; Borchman, D.; Georgiev, G.A. Effects of Lipid Saturation on the Surface Properties of Human Meibum Films. Int. J. Mol. Sci. 2018, 19, 2209. [Google Scholar] [CrossRef]
- Loglio, G.; Tesei, U.; Cini, R. Viscoelastic dilatation processes of fluid/fluid interfaces: Time-domain representation. Colloid Polym. Sci. 1986, 264, 712–718. [Google Scholar] [CrossRef]
- Monroy, F.; Ortega, F.; Rubio, R.G. Dilatational rheology of insoluble polymer monolayers: Poly(vinylacetate). Phys. Rev. 1998, 58, 7629–7641. [Google Scholar] [CrossRef]
- Daull, P.; Amrane, M.; Ismail, D.; Georgiev, G.; Cwiklik, L.; Baudouin, C.; Leonardi, A.; Garhofer, G.; Garrigue, J.S. Cationic Emulsion-Based Artificial Tears as a Mimic of Functional Healthy Tear Film for Restoration of Ocular Surface Homeostasis in Dry Eye Disease. J. Ocul. Pharmacol. Ther. Off. J. Assoc. Ocul. Pharmacol. Ther. 2020, 36, 355–365. [Google Scholar] [CrossRef]
- Davies, J.T.; Rideal, E.K. Chapter 5—Properties of Monolayers. In Interfacial Phenomena, 2nd ed.; Davies, J.T., Rideal, E.K., Eds.; Academic Press: Cambridge, MA, USA, 1961; pp. 217–281. [Google Scholar]
- Bhamla, M.S.; Chai, C.; Rabiah, N.I.; Frostad, J.M.; Fuller, G.G. Instability and Breakup of Model Tear Films. Investig. Ophthalmol. Vis. Sci. 2016, 57, 949–958. [Google Scholar] [CrossRef] [PubMed]
- Tsang, K.Y.; Ngai, K.L. Relaxation in interacting arrays of oscillators. Phys. Review. Stat. Phys. Plasmas Fluids Relat. Interdiscip. Top. 1996, 54, R3067–R3070. [Google Scholar] [CrossRef] [PubMed]
- Avramov, I. Kinetics of structural relaxation of glass-forming melts. Thermochim. Acta 1996, 280–281, 363–382. [Google Scholar] [CrossRef]
- Schmelzer, J.W.P.; Zanotto, E.D.; Avramov, I.; Fokin, V.M. Stress development and relaxation during crystal growth in glass-forming liquids. J. Non Cryst. Solids 2006, 352, 434–443. [Google Scholar] [CrossRef]
- Petrov, P.G.; Thompson, J.M.; Rahman, I.B.; Ellis, R.E.; Green, E.M.; Miano, F.; Winlove, C.P. Two-dimensional order in mammalian pre-ocular tear film. Exp. Eye Res. 2007, 84, 1140–1146. [Google Scholar] [CrossRef]
- Smaby, J.M.; Brockman, H.L. Novel surface phase containing cholesteryl esters. 2. Nonequivalence of cholesteryl arachidonate and those with 18-carbon, cis-unsaturated acyl groups. Biochemistry 1981, 20, 724–730. [Google Scholar] [CrossRef] [PubMed]
- Butovich, I.A.; Arciniega, J.C.; Wojtowicz, J.C. Meibomian lipid films and the impact of temperature. Investig. Ophthalmol. Vis. Sci. 2010, 51, 5508–5518. [Google Scholar] [CrossRef]
- Eftimov, P.; Olżyńska, A.; Melcrová, A.; Georgiev, G.A.; Daull, P.; Garrigue, J.S.; Cwiklik, L. Improving Stability of Tear Film Lipid Layer via Concerted Action of Two Drug Molecules: A Biophysical View. Int. J. Mol. Sci. 2020, 21, 9490. [Google Scholar] [CrossRef]
- Georgiev, G.A.; Gurov, R.; Jordanova, A.; Vassilieff, C.S.; Lalchev, Z. Properties of alkyl-phosphatidylcholine monolayers in the presence of surface-active three-block copolymers. Colloids Surf. B Biointerfaces 2010, 80, 40–44. [Google Scholar] [CrossRef]
- Arita, R.; Morishige, N.; Sakamoto, I.; Imai, N.; Shimada, Y.; Igaki, M.; Suzuki, A.; Itoh, K.; Tsubota, K. Effects of a warm compress containing menthol on the tear film in healthy subjects and dry eye patients. Sci. Rep. 2017, 7, 45848. [Google Scholar] [CrossRef]
- Brown, S.I.; Dervichian, D.G. The oils of the meibomian glands. Physical and surface characteristics. Arch. Ophthalmol. 1969, 82, 537–540. [Google Scholar] [CrossRef] [PubMed]
- Yokoi, N.; Bron, A.J.; Georgiev, G.A. The precorneal tear film as a fluid shell: The effect of blinking and saccades on tear film distribution and dynamics. Ocul. Surf. 2014, 12, 252–266. [Google Scholar] [CrossRef] [PubMed]
- Raju, S.R.; Palaniappan, C.K.; Ketelson, H.A.; Davis, J.W.; Millar, T.J. Interfacial dilatational viscoelasticity of human meibomian lipid films. Curr. Eye Res. 2013, 38, 817–824. [Google Scholar] [CrossRef] [PubMed]
- Yokoi, N.; Yamada, H.; Mizukusa, Y.; Bron, A.J.; Tiffany, J.M.; Kato, T.; Kinoshita, S. Rheology of tear film lipid layer spread in normal and aqueous tear-deficient dry eyes. Investig. Ophthalmol. Vis. Sci. 2008, 49, 5319–5324. [Google Scholar] [CrossRef] [PubMed]
- Goto, E.; Tseng, S.C. Differentiation of lipid tear deficiency dry eye by kinetic analysis of tear interference images. Arch. Ophthalmol. 2003, 121, 173–180. [Google Scholar] [CrossRef] [PubMed]
- Cohen, Y.; Trokel, S.; Arieli, Y.; Epshtien, S.; Gefen, R.; Harris, A. Mapping the Lipid Layer of the Human Tear Film. Cornea 2020, 39, 132–135. [Google Scholar] [CrossRef]
- Tiffany, J.M. The viscosity of human tears. Int. Ophthalmol. 1991, 15, 371–376. [Google Scholar] [CrossRef]
- Fatt, I. Observations of tear film break up on model eyes. CLAO J. 1991, 17, 267–281. [Google Scholar]

| Active Ingredients * | Oil Phase ** (9.12 × 10−3 M) |
|---|---|
| Povidone (3.96 × 10−5 M), Propylene Glycol (3.9 × 10−2 M) | Sesame Oil/Menthol/Polyoxyethylene 10 Castor Oil/Polyoxyl 40 Stearate/Poloxamer 407 = 1.15/0.12/3.2/4.6/0.04 |
| Film Composition | E, mN/m | τ, s | β | EEQ, mN/m |
|---|---|---|---|---|
| MGS | 71.705 | 59.86 | 0.486 | 40.03 |
| MGS (1.723 × 1016) + OP (0.344 × 1016) | 73.47 | 86.69 | 0.62 | 47.30 |
| MGS (1.723 × 1016) + OP (0.862 × 1016) | 74.23 | 86.62 | 0.628 | 48.60 |
| MGS (1.723 × 1016) + OP (1.723 × 1016) | 78.342 | 77.65 | 0.615 | 52.05 |
| Film Composition | E, mN/m | τ, s | β | EEQ, mN/m |
|---|---|---|---|---|
| MGS | 71.705 | 59.86 | 0.486 | 40.03 |
| MGS + MNT (0.344 × 1016) | 88.57 | 54.42 | 0.63 | 40.03 |
| MGS + MNT (0.862 × 1016) | 108.30 | 50.02 | 0.698 | 49.70 |
| MGS + MNT (1.723 × 1016) | 112.96 | 53.84 | 0.712 | 51.20 |
Publisher’s Note: MDPI stays neutral with regard to jurisdictional claims in published maps and institutional affiliations. |
© 2022 by the authors. Licensee MDPI, Basel, Switzerland. This article is an open access article distributed under the terms and conditions of the Creative Commons Attribution (CC BY) license (https://creativecommons.org/licenses/by/4.0/).
Share and Cite
Eftimov, P.; Yokoi, N.; Tsuji, K.; Peev, N.; Georgiev, G.A. Langmuir Trough Study of the Interactions of Tear Mimetic Eyedrop Formulation with Human Meibum Films. Appl. Sci. 2022, 12, 12095. https://doi.org/10.3390/app122312095
Eftimov P, Yokoi N, Tsuji K, Peev N, Georgiev GA. Langmuir Trough Study of the Interactions of Tear Mimetic Eyedrop Formulation with Human Meibum Films. Applied Sciences. 2022; 12(23):12095. https://doi.org/10.3390/app122312095
Chicago/Turabian StyleEftimov, Petar, Norihiko Yokoi, Kazuhiro Tsuji, Nikola Peev, and Georgi As. Georgiev. 2022. "Langmuir Trough Study of the Interactions of Tear Mimetic Eyedrop Formulation with Human Meibum Films" Applied Sciences 12, no. 23: 12095. https://doi.org/10.3390/app122312095
APA StyleEftimov, P., Yokoi, N., Tsuji, K., Peev, N., & Georgiev, G. A. (2022). Langmuir Trough Study of the Interactions of Tear Mimetic Eyedrop Formulation with Human Meibum Films. Applied Sciences, 12(23), 12095. https://doi.org/10.3390/app122312095

